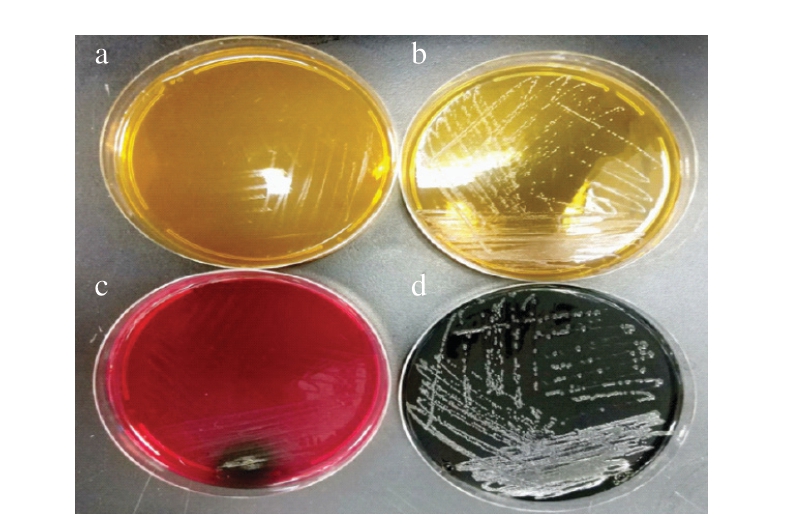

单核细胞增生李斯特氏菌是一种胞内寄生性人畜共患致病菌,可穿越宿主的肠道屏障、血脑屏障和胎盘屏障,在宿主细胞中存活并繁殖。动物和人类在摄入一定剂量的单核细胞增生李斯特氏菌后会患李斯特菌病,强毒株的半数致死剂量为2.57~3.67(lg(CFU))[1]。单核细胞增生李斯特氏菌在猪肉中可以达到的最大污染浓度(Nmax)由该菌的生长特性决定。迟滞时间(λ)、最大比生长速率(μmax)和Nmax等生长动力学参数是描述单核细胞增生李斯特氏菌生长特性的重要指标[2]。通过对单核细胞增生李斯特氏菌的生长动态进行数学建模可以获得该菌的生长动力学参数。
益生菌可作为生物栅栏因子,通过与致病菌接触时的信号分子交流、营养竞争及产生抑菌代谢产物抑制致病菌的生长[3]。Djenane等[4]的研究表明,清酒乳杆菌可以降低牛排中单核细胞增生李斯特氏菌的数量,并且对牛排的色泽与风味没有负面影响。Casale等[5]发现,乳酸乳杆菌可以抑制巴西白奶酪中单核细胞增生李斯特氏菌的生长,并且对白奶酪的物化性质没有影响。Prezzi[6]、Heredia-Castro[7]等指出,乳酸菌作为生物保护菌的首要条件是可在食品中生存繁殖,同时对食品品质无负面影响。
近些年来,两菌竞争抑制模型如Lotkae-Volterra模型(机理性交互模型)和Jameson-effect模型(经验性交互模型)已经被广泛应用到预测微生物学领域。机理性交互模型考虑到微生物整个生长阶段环境的动态变化[8-10],可以很好描述微生物间的交互作用,但是机理性模型包含的参数太多,模型建立过程比较复杂,在实际应用中不易实施。Lotkae-Volterra模型可能会高估细菌的λ,低估μmax,这会导致致病菌风险评估出现“失败-危险”的结果[11]。先前大量研究表明Jameson-effect模型适合描述同一环境中优势菌对劣势菌的抑制作用,经过修正扩展后的Jameson-effect模型适用于模拟多种环境条件下微生物间的交互作用[12-14]。
本研究选取产细菌素的益生菌植物乳杆菌植物亚种CICC6257(以下简称为植物乳杆菌CICC6257)为生物保护菌,首先研究该菌在猪肉中的生存能力及对其对猪肉pH值的影响,然后评估选择性培养基对单核细胞增生李斯特氏菌和植物乳杆菌CICC6257进行分离计数的能力,最后将植物乳杆菌CICC6257添加到猪肉中抑制单核细胞增生李斯特氏菌生长,应用Jameson-effect模型构建植物乳杆菌CICC6257对单核细胞增生李斯特氏菌的抑制模型,探究植物乳杆菌CICC6257对单核细胞增生李斯特氏菌λ、μmax和Nmax的影响。
1 材料与方法
1.1 材料与试剂
猪后腿瘦肉(2 kg) 上海卜蜂莲花超市(周家嘴路店)。
单核细胞增生李斯特氏菌(ATCC13932,血清型4b)由本实验室保藏;益生菌植物乳杆菌CICC6257购于中国工业微生物菌种保藏管理中心(http://www.chinacicc.org/)。植物乳杆菌CICC6257和单核细胞增生李斯特氏菌活化所用培养基为脑心浸液肉汤(brain heart infusion broth,BHIB)培养基;植物乳杆菌CICC6257的选择性增菌培养基为MRS肉汤(MRS broth,MRSB)培养基,单核细胞增生李斯特氏菌的选择性增菌培养基为胰酪胨大豆酵母浸膏肉汤(tryptic soy broth with yeast extract,TSB-YE)培养基;用于植物乳杆菌CICC6257和单核细胞增生李斯特氏菌分离计数的培养基分别为MRS琼脂(MRS agar,MRSA)和PALCAM琼脂,以上培养基均购自青岛海博生物技术有限公司。
氯化钠、体积分数75%乙醇溶液、无水乙醇、甘油、细菌培养皿、无菌均质袋、封口膜和试管均购自青岛海博生物技术有限公司。
1.2 仪器与设备
YXQ-LS-S2型灭菌锅 上海博讯实业有限公司;HLQ-8型斩拌机 安徽华菱西厨装备有限公司;SW-CJ-IFD型生物安全柜 江苏苏州安泰空气技术有限公司;THZ-103B型恒温培养摇床 上海一恒科学仪器有限公司;HWS-250型恒温恒湿培养箱 上海比朗仪器有限公司;JJ500型电子天平 江苏常熟市双杰测试仪器厂;XW-80A型漩涡混合器 上海精科实业有限公司;Bagmixer 400型无菌均质机 法国Interscience公司;10型pH计 浙江力辰科技有限公司;DW-300型实验室纯水系统 上海和泰仪器有限公司。
1.3 方法
1.3.1 细菌培养和接种液制备
单核细胞增生李斯特氏菌和植物乳杆菌CICC6257接种液的制备过程如下:实验前1 d,用灭菌的接种环分别从4 ℃冰箱保存的TSB-YE和MRSB培养基上挑取1 株菌苔,分别接种于100 mL BHIB培养基中。单核细胞增生李斯特氏菌在37 ℃、110 r/min的摇床上培养18 h,植物乳杆菌CICC6257在37 ℃的培养箱中静置培养18 h,使细菌生长到稳定期。然后分别取10 mL单核细胞增生李斯特氏菌和植物乳杆菌CICC6257的菌悬液在冷冻离心机中离心(4 ℃、8 000 r/min、5 min)收集菌体,菌体分别用10 mL无菌生理盐水重悬,重复2 次。最后用无菌生理盐水分别将单核细胞增生李斯特氏菌和植物乳杆菌CICC6257菌液稀释到104~105 CFU/mL和106~107 CFU/mL左右备用。
1.3.2 植物乳杆菌CICC6257在猪肉中的生长能力测定
实验前将整块的猪后腿瘦肉切成小块,放在用体积分数75%乙醇溶液擦拭灭菌过的斩拌机中斩拌3 min,将制得的肉糜放在预先紫外杀菌的托盘里,转移到无菌操作台中,紫外辐照1 h,期间每隔15 min翻动肉糜,使肉糜的外部和内部都能被紫外辐射灭菌。
在生物安全柜中,称取已灭菌的猪肉(25 g/份)分装在无菌均质袋中,每份猪肉接种1 mL植物乳杆菌CICC6257菌液。将接种菌液的猪肉用无菌均质机正反面各拍打2 min,使得菌液在猪肉中均匀分布。植物乳杆菌CICC6257的接种浓度约为105 CFU/g,确切初始接种量由平板计数法确认。将均质袋中的猪肉转移到经紫外杀菌的气调保鲜盒中进行无菌空气包装,然后将包装好的猪肉放置在13 ℃恒温恒湿培养箱中(相对湿度55%)培养。每隔适宜时间取样对植物乳杆菌CICC6257进行计数,计数培养基为MRSA培养基。
1.3.3 植物乳杆菌CICC6257接种猪肉pH值的测定
乳酸菌菌体及其产生的代谢产物可能会影响猪肉的感官品质,主要是产生的有机酸会引起猪肉pH值的变化。检测植物乳杆菌CICC6257对猪肉pH值的影响,未经处理的猪肉作为对照组,直接用pH计插入猪肉中进行pH值测定。
1.3.4 选择性培养基的验证
按照1.3.1节所述制备单核细胞增生李斯特氏菌和植物乳杆菌CICC6257生长到稳定期的接种液。用灭菌后的接种环蘸取单核细胞增生李斯特氏菌的接种液在MRSA和PALCAM培养基上分别划线培养分离单菌落,同时蘸取植物乳杆菌CICC6257的接种液分别在MRSA和PALCAM培养基上分别划线。将划线后的培养皿倒置放在37 ℃培养箱中培养48 h后,观察细菌菌落形成情况,拍照记录。
1.3.5 植物乳杆菌CICC6257和单核细胞增生李斯特氏菌在猪肉中的生长特性测定
将已灭菌的猪肉按照25 g/份放置在均质袋中,分成以下3 组:1)阴性对照组,每份猪肉接种2 mL无菌生理盐水;2)单核细胞增生李斯特氏菌单独接种组(对照组),每份猪肉接种2 mL单核细胞增生李斯特氏菌(1 mL)和无菌生理盐水(1 mL)的混合液;3)单核细胞增生李斯特氏菌和植物乳杆菌CICC6257共同接种组(处理组),每份猪肉接种2 mL植物乳杆菌CICC6257(1 mL)和单核细胞增生李斯特氏菌(1 mL)的混合液。
将接种菌液的猪肉用无菌均质机正反面各拍打2 min,使得菌液在猪肉中均匀分布。单核细胞增生李斯特氏菌和植物乳杆菌CICC6257的确切初始接种量用平板计数法确认。将均质袋中的猪肉转移到经紫外杀菌的气调保鲜盒中进行无菌空气包装,然后将包装好的猪肉放置在13 ℃恒温恒湿培养箱中培养。在适宜间隔取样对猪肉中单核细胞增生李斯特氏菌和植物乳杆菌CICC6257进行计数,计数方法如下:在无菌条件下,将气调保鲜盒中的猪肉转移到含有225 mL无菌生理盐水的均质袋中,然后在均质机上拍打2 min,使细菌充分散落在匀浆中。用10 倍稀释法进行梯度稀释,选择2~3 个适宜稀释度的菌悬液,用移液枪吸取100 μL涂布在预先准备好的PALCAM和MRSA选择性培养基上,待培养皿晾干之后,倒置放在37 ℃培养箱中培养48 h,用细胞计数器进行计数。为检测紫外辐照杀灭猪肉中背景菌的效果,将阴性对照组的均质液涂布在TSA平板上,培养条件与计数方法同上。
1.3.6 植物乳杆菌CICC6257对猪肉中单核细胞增生李斯特氏菌抑制模型的建立
1.3.6.1 一级模型的构建
选用Baranyi模型[15]构建植物乳杆菌CICC6257和单核细胞增生李斯特氏菌生长的一级模型,见式(1)~(3):

式中:Y0、Y(t)和Ymax分别为初始时刻、t时刻和达到稳定期时的单核细胞增生李斯特氏菌菌落总数(ln(CFU/g));μmax为最大比生长速率/(ln(CFU/g))-h;λ为细菌生长的迟滞时间/h。
1.3.6.2 抑制模型的构建
应用修正的Jameson-effect模型构建植物乳杆菌CICC6257对单核细胞增生李斯特氏菌的抑制模型,模型的建立分为3 步:首先,应用传统的Baranyi模型拟合得到植物乳杆菌CICC6257与单核细胞增生李斯特氏菌共同培养时两菌的生长动力学参数;其次,将得到的两菌生长动力学参数应用到修正的Jameson-effect模型中,拟合得到抑制系数γ和Nmax;最后,应用MATLAB软件编写程序,模拟植物乳杆菌CICC6257对单核细胞增生李斯特氏菌的抑制作用图。修正的Jameson-effect模型见式(4)~(7)[16]:

式中:μmax-Lm和μmax-Lp分别为单核细胞增生李斯特氏菌和植物乳杆菌CICC6257的最大比生长速率(ln(CFU/g))-h;Lm(t)和Lp(t)分别为单核细胞增生李斯特氏菌和植物乳杆菌CICC6257在t时刻的菌落总数(lg(CFU/g));qLm(t)和qLp(t)分别为单核细胞增生李斯特氏菌和植物乳杆菌CICC6257在t时刻的生理状态(q=μt/μmax);Nmax-Lm和Nmax-Lp分别为单核细胞增生李斯特氏菌和植物乳杆菌CICC6257的最大菌落总数(lg(CFU/g))。植物乳杆菌CICC6257达到最大菌落总数后,若γ<1,单核细胞增生李斯特氏菌继续生长,菌落总数增加;若γ>1,菌落总数减小;若γ=1,单核细胞增生李斯特氏菌停止生长。
1.3.6.3 抑制模型的数学评价
应用准确因子(accuracy factor,Af)、偏差因子(bias factor,Bf)和均方根误差(root mean square error,RMSE)对构建的抑制模型进行数学评价。Af、Bf和RMSE分别按式(8)~(10)计算:

式中:n为观察的数据点个数;Np为细菌菌落总数的预测值(lg(CFU/g));No为细菌菌落总数的观察值(lg(CFU/g))。
1.4 数据处理
应用Microsoft Excel 2010将单核细胞增生李斯特氏菌菌落数单位CFU/g转换为(lg(CFU/g))。应用Microrisk Lab软件(https://www.microrisklab.top/)拟合单核细胞增生李斯特氏菌和植物乳杆菌CICC6257的一级生长模型,得到单核细胞增生李斯特氏菌和植物乳杆菌CICC6257的λ和μmax,应用MATLAB R2016a软件(美国MathWorks公司)构建植物乳杆菌CICC6257对单核细胞增生李斯特氏菌的抑制模型。每个实验至少做3 次独立重复实验。应用SPSS 17.0软件(美国IBM公司)进行数据显著性分析。
2 结果与分析
2.1 植物乳杆菌CICC6257在猪肉中的生长特性
本研究涉及全程非冷链运输模型,根据EcoSure[17]对市售冷鲜猪肉环境的调研数据,冷鲜保藏环境温度在-6.67~19.44 ℃之间,因此本研究选取13 ℃研究益生菌对猪肉中单核细胞增生李斯特氏菌的抑制特性,以达到高估风险的目的。
由图1可知,植物乳杆菌CICC6257生长缓慢,在60 h左右生长到稳定期。植物乳杆菌CICC6257在13 ℃贮藏猪肉中生长状况良好,具有用作生物保护菌抑制猪肉中单核细胞增生李斯特氏菌生长的潜力。植物乳杆菌CICC6257是国家公布的可用于添加到食品中的益生菌之一[18]。本研究所用植物乳杆菌CICC6257是产细菌素的益生菌,Gao Quanxin等[19]指出植物乳杆菌CICC6257的脂磷壁酸还可以缓解由鳗弧菌诱导的银鲳鱼炎症和凋亡。并不是所有的乳酸菌都具有作为生物保护菌的潜力,如Li Peijun等[20]测试6 株乳酸菌对新鲜鸡胸肉中梭状芽孢杆菌的抑制作用,发现戊糖片球菌虽然能够抑制梭状芽孢杆菌的生长,但是显著降低了鲜鸡肉的pH值,因此不适宜作为生物保护菌应用在鸡肉中。

图1 13 ℃贮藏猪肉中植物乳杆菌CICC6257的生长特性
Fig. 1 Growth of L. plantarum CICC6257 in pork meat at 13 ℃
2.2 植物乳杆菌CICC6257对猪肉pH值的影响
GB/T 9695.5—2008《肉与肉制品 pH测定》[21]规定猪肉的pH值在5.8~6.2之间为新鲜肉,在6.3~6.6之间为次鲜肉,在6.7以上为变质肉。由图2可知,13 ℃贮藏72 h时,对照组猪肉的pH值显著增加到6.75(P<0.05),成为变质肉;处理组猪肉的pH值先轻微下降,然后上升,处理组猪肉贮藏后期的pH值和贮藏初期无显著差异(P≥0.05)。Huang Shirong等[22]研究超临界CO2结合迷迭香对4 ℃贮藏猪肉品质的影响,同样发现在贮藏的第7天,对照组猪肉pH值从初始值5.75升高到7.20。朱亚[23]、Bohrer[24]、Vaskoska[25]等也发现猪肉贮藏期间pH值上升的现象。

图2 植物乳杆菌CICC6257对13 ℃贮藏猪肉pH值的影响
Fig. 2 Influence of L. plantarum CICC6257 on the pH of pork at 13 ℃
小写字母不同表示同组、不同贮藏时间差异显著(P<0.05)。
在13 ℃贮藏初期,处理组猪肉的pH值呈下降趋势。随着贮藏时间延长,猪肉的pH值又呈现上升趋势,这是因为贮藏后期猪肉中的蛋白质分解产生碱性物质[26],中和了植物乳杆菌CICC6257产生的酸性物质。Hernández-Aquino等[27]详细研究多种植物乳杆菌CICC6257对猪肉品质的影响,对猪肉进行感官评定,并对猪肉pH值进行测定,发现不同植物乳杆菌CICC6257对猪肉品质的影响效果不同。本研究所选植物乳杆菌CICC6257不仅在猪肉中生长状态良好,且对猪肉pH值的影响较小,因此将该株植物乳杆菌CICC6257作为生物保护菌控制肉制品中的单核细胞增生李斯特氏菌有巨大的发展潜力和应用前景。
2.3 选择性培养基的确认
由图3可知,单核细胞增生李斯特氏菌在MRSA培养基上不生长,植物乳杆菌CICC6257在MRSA培养基上为白色圆点状。植物乳杆菌CICC6257在PALCAM培养基上不生长,只在一区(菌液最多的地方)形成黑色印记,没有完整的单菌落形成。单核细胞增生李斯特氏菌在PALCAM选择性培养基上呈现圆形的黑灰色菌落,菌落外围有棕黑色的水解圈,将整个培养基晕成黑色。
图3 植物乳杆菌CICC6257和单核细胞增生李斯特氏菌在MRSA和PALCAM培养基上的菌落形态
Fig. 3 Colony morphology of L. plantarum CICC6257 and L. monocytogenes on MRSA and PALCAM media
a.单核细胞增生李斯特氏菌在MRSA培养基上;b.植物乳杆菌CICC6257在MRSA培养基上;c.植物乳杆菌CICC6257在PALCAM培养基上;d.单核细胞增生李斯特氏菌在PALCAM培养基上。
微生物一级生长模型的实质是对细菌菌落数随时间的变化进行数学建模,需要在整个实验阶段监测目标菌落随时间的变化,细菌计数的精确性对模型的准确性有很大影响。如果实验基质中只有1 种菌,用基础的含有碳源、氮源和其他细菌所需成分的培养基即可。当2 种甚至更多种细菌共同存在时,需要用选择性培养基将目标细菌选择分离出来[28]。本实验所用猪肉为紫外辐照灭菌后经检验不含背景菌的猪肉,因此不考虑猪肉中含有其他杂菌的情况。由图3可知,MRSA和PALCAM培养基能够作为选择性培养基,对混合培养的单核细胞增生李斯特氏菌和植物乳杆菌CICC6257进行分离计数。
2.4 植物乳杆菌CICC6257对单核细胞增生李斯特氏菌的抑制作用
阴性对照组中无菌落检出,说明猪肉灭菌效果良好。由图4可知,和对照组相比,处理组单核细胞增生李斯特氏菌生长缓慢,且Nmax较低,这是因为处理组的益生菌植物乳杆菌CICC6257发酵糖类后,产生乳酸和乙酸等有机酸,这些有机酸可与单核细胞增生李斯特氏菌细胞膜结构中的磷脂及脂多糖作用,进而破坏该菌的细胞膜结构,最终抑制细菌的生长[29]。另外,食品基质pH值降低导致H+在单核细胞增生李斯特氏菌细胞内聚集,细胞膜上质子电化学势梯度的改变破坏了细菌的跨膜运输系统[30];H+聚集在细胞内造成胞内渗透压升高,胞内微环境的改变影响细菌酶的活性,干扰DNA合成、RNA转录等进程[31];细菌主动运输H+会消耗大量能量、使其生长代谢速率降低等原因都会造成处理组单核细胞增生李斯特氏菌生长缓慢[32]。处理组中植物乳杆菌CICC6257到达稳定期后,单核细胞增生李斯特氏菌继续生长一段时间后停止生长。这是因为植物乳杆菌CICC6257生长到稳定期后,通过与单核细胞增生李斯特氏菌竞争营养、接触时的信号分子交流、产生大量抑菌代谢产物抑制了该菌的生长[3]。

图4 植物乳杆菌CICC6257对13 ℃贮藏猪肉中单核细胞增生李斯特氏菌的抑制作用
Fig. 4 Inhibitory effect of L. plantarum CICC6257 on L. monocytogenes in pork at 13 ℃
为更深入研究植物乳杆菌CICC6257对单核细胞增生李斯特氏菌生长特性的影响,需要进一步对一级模型拟合得到的单核细胞增生李斯特氏菌λ、μmax和Nmax进行统计学分析。
2.5 植物乳杆菌CICC6257对单核细胞增生李斯特氏菌λ、μmax和Nmax的影响
用Baranyi模型拟合单核细胞增生李斯特氏菌和植物乳杆菌CICC6257单独及混合培养时的生长曲线,得到两菌的λ、μmax和Nmax见表1。和对照组相比,处理组单核细胞增生李斯特氏菌的λ较长,μmax也较低,但是没有显著差异(P≥0.05);而处理组单核细胞增生李斯特氏菌的Nmax比对照组显著降低0.75(lg(CFU/g))(P<0.05)。初始接种量约为5(lg(CFU/g))的植物乳杆菌CICC6257可以在13 ℃条件下显著降低单核细胞增生李斯特氏菌的Nmax(P<0.05)。根据Jamesoneffect理论,处于同一系统中的微生物种群会竞争有限的资源,当优势菌群达到最大浓度时,会抑制劣势菌群的生长[33-36]。将植物乳杆菌CICC6257接种较高的浓度使其成为优势菌群以抑制单核细胞增生李斯特氏菌的生长,同时,植物乳杆菌CICC6257和单核细胞增生李斯特氏菌细胞接触时的信息交流及植物乳杆菌CICC6257产生的抑菌代谢产物也抑制了单核细胞增生李斯特氏菌的生长[37]。本研究结果还表明,植物乳杆菌CICC6257的生长不受单核细胞增生李斯特氏菌影响(图1、4),有潜力作为生物保护菌抑制猪肉中单核细胞增生李斯特氏菌的生长。
表1 Baranyi模型拟合得到的13 ℃贮藏猪肉中植物乳杆菌CICC6257和单核细胞增生李斯特氏菌的生长参数
Table 1 Parameters estimated from Baranyi model for the growth of L. plantarum CICC6257 and L. monocytogenes in pork at 13 ℃

注:同列小写字母不同表示组间差异显著。
菌种及培养方式λ/hμmax/(lg(CFU/g))-h Nmax(lg(CFU/g))对照组单核细胞增生李斯特氏菌10.68±0.32a0.09±0.01a7.23±0.15b处理组单核细胞增生李斯特氏菌11.09±1.53a0.07±0.01a6.48±0.11a处理组植物乳杆菌CICC62578.18±3.680.09±0.027.41±0.04
2.6 植物乳杆菌CICC6257对单核细胞增生李斯特氏菌抑制模型的建立及评价
由表2可知,植物乳杆菌CICC6257对单核细胞增生李斯特氏菌的γ为0.79,说明在植物乳杆菌CICC6257达到稳定期后,单核细胞增生李斯特氏菌的菌落总数增加。由图4可知,植物乳杆菌CICC6257达到稳定期后,单核细胞增生李斯特氏菌继续缓慢生长了一段时间后才停止生长。
表2 Jameson-effect模型拟合得到的单核细胞增生李斯特氏菌Nmax、模型的抑制系数(γ)和评价参数
Table 2 Nmax, inhibition coefficient (γ) and evaluation parameters of the established Jameson-effect model

γNmax(lg(CFU/g))评价指标实测值预测值AfBfRMSE 0.796.467.241.050.960.26
包含γ的Jameson-effect模型能够更好地描述优势菌群对劣势菌群的抑制作用,如董庆利等[38]用改良的Jamesoneffect模型建立5 种温度条件下植物乳杆菌CICC6257对单核细胞增生李斯特氏菌的抑制模型,Mejlholm等[13]应用含有γ的Jameson-effect模型构建蛋黄酱海鲜沙拉中乳酸菌对单核细胞增生李斯特氏菌的抑制模型,Quinto等[39]应用含有γ的Jameson-effect模型建立肉汁中不同清酒乳杆菌对单核细胞增生李斯特氏菌的抑制模型,Møller等[40]应用含有γ的Jameson-effect模型建立鲜肉中背景菌和沙门氏菌的交互模型。Marc等[41]发现,修正后的Jameson-effect模型更适用于描述牛奶中乳酸菌对金黄色葡萄球菌的抑制作用。以上研究表明,在混合培养时,优势菌达到稳定期后,γ可以对劣势菌的浓度变化作出准确的预测。建立植物乳杆菌CICC6257对单核细胞增生李斯特氏菌的抑制模型后,可以根据一级Baranyi模型得到的植物乳杆菌CICC6257和单核细胞增生李斯特氏菌的λ和μmax预测任意时刻植物乳杆菌CICC6257对单核细胞增生李斯特氏菌的抑制情况,进而监控两菌的生长动态。
由图5可知,改良的Jameson-effect模型能够很好地描述植物乳杆菌CICC6257对单核细胞增生李斯特氏菌的抑制作用,两菌的生长都呈现出迟滞期、指数生长期和稳定期3 个阶段。植物乳杆菌CICC6257和单核细胞增生李斯特氏菌共培养时,单核细胞增生李斯特氏菌菌落总数远低于植物乳杆菌CICC6257。在猪肉中,植物乳杆菌CICC6257作为优势菌抑制单核细胞增生李斯特氏菌的生长,植物乳杆菌CICC6257生长到达稳定期后,单核细胞增生李斯特氏菌继续生长,这和γ的预测结果一致。建立的抑制模型RMSE为0.26,Af和Bf分别为1.05和0.96,说明Jameson-effect模型能够很好地描述植物乳杆菌CICC6257对单核细胞增生李斯特氏菌的抑制作用[42]。

图5 Jameson-effect模型模拟13 ℃贮藏猪肉中植物乳杆菌CICC6257对单核细胞增生李斯特氏菌的抑制作用
Fig. 5 The Jameson-effect model was fitted to the inhibitory effect of L. plantarum CICC6257 on L. monocytogenes in pork at 13 ℃
为满足消费者对“轻加工”及“安全、营养”食品的要求,生物抑菌法引起越来越多人的关注。益生菌对单核细胞增生李斯特氏菌生长的抑制作用已在乳制品、肉制品及果蔬等食品中得到验证。目前在进行理论研究时往往会去除背景菌,且不考虑食品基质和背景菌群对建模结果的影响,以期更准确地探究乳酸菌作为抑菌手段的有效性,但是这可能会影响模型的准确性,导致高估或低估单核细胞增生李斯特氏菌的风险[39-41]。真实食品基质营养成分复杂,且在实际食品环境中往往多菌共存,这些环境条件对致病菌的生长存在一定的影响[35],后续可在两菌交互模型建立的理论基础上将这些环境参数都纳入模型,对模型进行修正扩展,以期对实际食品中益生菌与单核细胞增生李斯特氏菌的关系作出更准确的预测。
3 结论
应用在食品中的益生菌需具有较高的活性,能够在食品中生存和繁殖,并且不能对食品的感官品质产生较大的负面影响。植物乳杆菌CICC6257在猪肉中生长良好,并且在货架期内对猪肉pH值无显著影响(P≥0.05)。植物乳杆菌CICC6257可以将13 ℃贮藏猪肉中单核细胞增生李斯特氏菌的Nmax降低0.75(lg(CFU/g)),但是对单核细胞增生李斯特氏菌的λ和μmax无显著影响(P≥0.05),可将植物乳杆菌CICC6257与其他抑菌技术如气调包装、益生元和苯甲酸钠等联用,以更好地提高食品的微生物安全。另外,本研究建立的Jameson-effect模型能够很好地描述将食品基质背景菌消除后植物乳杆菌CICC6257对单核细胞增生李斯特氏菌的抑制作用,但是实际食品中多种微生物共存,它们之间相互影响。后续可在两菌交互模型建立的理论基础上研究实际食品状态下益生菌对单核细胞增生李斯特氏菌的抑制作用,并且评估食品中菌群结构的改变及食品品质的变化,这对推进益生菌在保护肉类产品安全领域的进一步应用具有十分重要的现实意义。
[1] POUILLOT R, KIERMEIER A, GUILLIER L, et al. Updated parameters for Listeria monocytogenes dose-response model considering pathogen virulence and age and sex of consumer[J].Foods, 2024, 13(5): 751. DOI:10.3390/foods13050751.
[2] 张文敏, 董庆利, 辛宝, 等. 猪肉制品中单增李斯特菌污染现状及致病力控制分析[J]. 食品与发酵工业, 2023, 49(17): 299-307.DOI:10.13995/j.cnki.11-1802/ts.033859.
[3] 鲁新新, 李卓思, 高彬茹, 等. 乳酸菌与单增李斯特菌竞争生长机制与建模研究进展[J]. 生物加工过程, 2023, 21(6): 683-690.DOI:10.3969/j.issn.1672-3678.2023.06.012.
[4] DJENANE D, MARTÍNEZ L, SÁNCHEZ-ESCALANTE A, et al.Effect of lactic acid bacteria on beef steak microbial flora stored under modified atmosphere and on Listeria monocytogenes in broth cultures[J]. Food Science and Technology International, 2016, 12: 287-295. DOI:10.1177/1082013206067788.
[5] CASALE A L, FRANCA L E M, GABRIELA P, et al. Listeria monocytogenes inhibition by lactic acid bacteria and coliforms in Brazilian fresh white cheese[J]. Brazilian Journal of Microbiology,2021, 52: 847-858. DOI:10.1007/s42770-021-00431-4.
[6] PREZZI L E, LEE S H I, NUNES V M R, et al. Effect of Lactobacillus rhamnosus on growth of Listeria monocytogenes and Staphylococcus aureus in a probiotic Minas Frescal cheese[J]. Food Microbiology,2020, 92: 103557. DOI:10.1016/j.fm.2020.103557.
[7] HEREDIA-CASTRO P Y, REYES-DÍAZ R, RENDÓN-ROSALES M Á,et al. Novel bacteriocins produced by Lactobacillus fermentum strains with bacteriostatic effects in milk against selected indicator microorganisms[J]. Journal of Dairy Science, 2021, 104(4): 4033-4043. DOI:10.3168/jds.2020-19531.
[8] CHEN Y M, WANG X, ZHANG X B, et al. Modeling the interactions among Salmonella enteritidis, Pseudomonas aeruginosa and Lactobacillus plantarum[J]. Journal of Food Safety, 2020, 40(4):e12811. DOI:10.1111/jfs.12811.
[9] BOLÍVAR A, TARLAK F, COSTA J C C P, et al. A new expanded modelling approach for investigating the bioprotective capacity of Latilactobacillus sakei CTC494 against Listeria monocytogenes in ready-to-eat fish products[J]. Food Research International, 2021, 147:110545. DOI:10.1016/j.foodres.2021.110545.
[10] COSTA J C C P, BOLÍVAR A, VALERO A, et al. Evaluation of the effect of Lactobacillus sakei strain L115 on Listeria monocytogenes at different conditions of temperature by using predictive interaction models[J]. Food Research International, 2020, 131: 108928.DOI:10.1016/j.foodres.2019.108928.
[11] HUANG L H, HWANG C A, LIU Y H, et al. Growth competition between lactic acid bacteria and Listeria monocytogenes during simultaneous fermentation and drying of meat sausages: a mathematical modeling[J]. Food Research International, 2022, 158:111553. DOI:10.1016/j.foodres.2022.111553.
[12] COSTA J C C P, BOVERCID S, BOLÍVAR A, et al. Modelling the interaction of the sakacin-producing Lactobacillus sakei CTC494 and Listeria monocytogenes in filleted gilthead sea bream (Sparus aurata) under modified atmosphere packaging at isothermal and nonisothermal conditions[J]. International Journal of Food Microbiology,2019, 297: 72-84. DOI:10.1016/j.ijfoodmicro.2019.03.002.
[13] MEJHOLM O, DALGAARD P. Modelling and predicting the simultaneous growth of Listeria monocytogenes and psychrotolerant lactic acid bacteria in processed seafood and mayonnaise-based seafood salads[J]. Food Microbiology, 2015, 46: 1-14. DOI:10.1016/j.fm.2014.07.005.
[14] OSTERGAARD N B, EKLOW A, DALGAARD P. Modelling the effect of lactic acid bacteria from starter- and aroma culture on growth of Listeria monocytogenes in cottage cheese[J]. International Journal of Food Microbiology, 2014, 188: 15-25. DOI:10.1016/j.ijfoodmicro.2014.07.012.
[15] BARANYI J, ROBERTS T A. A dynamic approach to predicting bacterial growth in food[J]. International Journal of Food Microbiology,1994, 23(3): 277-294. DOI:10.1016/0168-1605(94)90157-0.
[16] JAMESON J E. A discussion of the dynamics of Salmonella enrichment[J]. Journal of Hygiene, 1962, 60(2): 193-207.DOI:10.1017/s0022172400039462.
[17] EcoSure. EcoSure 2007 cold temperature database[EB/OL]. (2008-10-15)[2017-06-26]. http://foodrisk.org/exclusives/EcoSure/.
[18] 卫生部. 卫生部办公厅关于印发《可用于食品的菌种名单》的通知[S]. [2010-04-22]. http://www.nhc.gov.cn/sps/s3593/201004/65839d 2d57554dd29ae40a52dca92c74.shtml.
[19] GAO Q X, GAO Q B, MIN M M, et al. Ability of Lactobacillus plantarum lipoteichoic acid to inhibit Vibrio anguillarum-induced inflammation and apoptosis in silvery pomfret (Pampus argenteus)intestinal epithelial cells[J]. Fish and Shellfish Immunology, 2016, 54:573-579. DOI:10.1016/j.fsi.2016.05.013.
[20] LI P J, JIA S S, ZHOU C L, et al. Protective role of Lactobacillus fermentum R6 against Clostridium perfringens in vitro and in chicken breast meat under temperature abuse conditions[J]. Innovative food Science and Emerging Technologies, 2017, 41: 117-123. DOI:10.1016/j.ifset.2017.03.001.
[21] 中国商业联合会商业标准中心, 国家加工食品质量监督检验中心(广州), 广州市产品质量监督检验所. 肉与肉制品 pH测定: GB/T 9695.5—2008[S]. 北京: 中国标准出版社, 2008.
[22] HUANG S R, LIU B, GE D, et al. Effect of combined treatment with supercritical CO2 and rosemary on microbiological and physicochemical properties of ground pork stored at 4 ℃[J]. Meat Science, 2017, 125: 114-120. DOI:10.1016/j.meatsci.2016.11.022.
[23] 朱亚, 宋纪霖. 天然复合保鲜剂对冷鲜肉感官品质和理化指标的影响[J]. 陕西农业科学, 2018, 64(10): 89-92. DOI:10.3969/j.issn.0488-5368.2018.10.027.
[24] BOHRER B M, WANG Y, DORLEKU J B, et al. Pork muscle profiling: pH and instrumental color of the longissimus thoracis is not representative of pH and instrumental color of shoulder and ham muscles[J]. Food Science & Technology, 2024, 208: 109380.DOI:10.1016/j.meatsci.2023.109380.
[25] VASKOSKA R, HA M, WHITE J D, et al. Benefits of prolonged ageing for the quality of Australian pork depends on cooking temperature and meat pH[J]. Animal Production Science, 2023, 63(8):816-823. DOI:10.1071/AN22389.
[26] 常海军, 石源伟, 伯朝英, 等. 氧化条件下姜黄素对猪肉肌原纤维蛋白理化和凝胶特性的影响[J]. 食品科学, 2024, 45(8): 63-71.DOI:10.7506/spkx1002-6630-20230709-083.
[27] HERNÁNDEZ-AQUINO S, MIRANDA-ROMERO L A, FUJIKAWA H,et al. Antibacterial activity of lactic acid bacteria to improve shelf life of raw meat[J]. Biocontrol Science, 2019, 24(4): 185-192.DOI:10.4265/bio.24.185.
[28] KAUSHIK A, TANEJA N K, JUNEJA V K, et al. Enhancing microbial safety and quality of milk with ultrasonication: kinetics modeling of pathogenic bacteria and milk characteristics[J]. LWT-Food Science and Technology, 2024, 202(15): 116-287. DOI:10.1016/j.lwt.2024.116287.
[29] HSIAO C P, SIEBERT K J. Modeling the inhibitory effects of organic acids on bacteria[J]. International Journal of Food Microbiology, 1999,47(3): 189-201. DOI:10.1016/S0168-1605(99)00012-4.
[30] ALAKOMI H L, SKYTTÄ E, SAARELA M, et al. Lactic acid permeabilizes gram-negative bacteria by disrupting the outer membrane[J]. Applied and Environmental Microbiology, 2000, 66(5):2001-2005. DOI:10.1128/AEM.66.5.2001-2005.2000.
[31] ASURMENDI P, GARCÍA M J, PASCUAL L, et al. Biocontrol of Listeria monocytogenes by lactic acid bacteria isolated from brewer grains used as feedstuff in Argentina[J]. Journal of Stored Products Research, 2015, 61: 27-31. DOI:10.1016/j.jspr.2015.02.001.
[32] 张哲川, 梁晓琳, 张玉双, 等. 浆水发酵过程中有机酸的变化及其抑菌性能和体外抗氧化能力[J]. 中国食品学报, 2024, 24(4): 159-169.DOI:10.16429/j.1009-7848.2024.04.016.
[33] PEDREIRA A, MARTÍNEZ-LÓPEZ N, VÁZQUEZ J A, et al.Modelling the antimicrobial effect of food preservatives in bacteria:application to Escherichia coli and Bacillus cereus inhibition with carvacrol[J]. Journal of Food Engineering, 2024, 361: 111734.DOI:10.1016/j.jfoodeng.2023.111734.
[34] GONZALES-BARRON U, CAMPAGNOLLO F B, SCHAFFNER D W,et al. Behavior of Listeria monocytogenes in the presence or not of intentionally-added lactic acid bacteria during ripening of artisanal Minas semi-hard cheese[J]. Food Microbiology, 2020, 91: 103545.DOI:10.1016/j.fm.2020.103545.
[35] TIRLONI E, BERNARDI C, CELANDRONI F, et al. Effectiveness of lactic and acetic acids on the growth of Listeria monocytogenes and Bacillus cereus in primo sale fresh cheese[J]. LWT-Food Science and Technology, 2021, 151: 112170. DOI:10.1016/j.lwt.2021.112170.
[36] SERRA-CASTELLÓ C, COSTA J C C P, JOFRÉ A, et al.A mathematical model to predict the antilisteria bioprotective effect of Latilactobacillus sakei CTC494 in vacuum packaged cooked ham[J].Journal of Food Microbiology, 2022, 363(16): 109491. DOI:10.1016/j.ijfoodmicro.2021.109491.
[37] 康慎敏, 武瑞赟, 穆文强, 等. 乳酸菌拮抗食源性致病菌的研究及应用进展[J]. 食品科学, 2022, 43(1): 250-259. DOI:10.7506/spkx1002-6630-20210526-326.
[38] 董庆利, 张文敏, 宋筱瑜, 等. 应用改良的Jameson-effect模型建立植物乳杆菌对单增李斯特菌的抑制模型[J]. 现代食品科技, 2016,32(9): 135-140. DOI:10.13982/j.mfst.1673-9078.2016.9.020.
[39] QUINTO E J, MARIN J M, SCHAFFNER D W. Effect of the competitive growth of Lactobacillus sakei MN on the growth kinetics of Listeria monocytogenes Scott A in model meat gravy[J]. Food Control, 2016, 63: 34-45. DOI:10.1016/j.foodcont.2015.11.025.
[40] MØLLER C O, LLG Y, AABO S, et al. Effect of natural microbiota on growth of Salmonella spp. in fresh pork-a predictive microbiology approach[J]. Food Microbiology, 2013, 34(2): 284-295. DOI:10.1016/j.fm.2012.10.010.
[41] MARC L Y, VALÍK L, MEDVEDOVÁ A. Modelling the effect of the starter culture on the growth of Staphylococcus aureus in milk[J].International Journal of Food Microbiology, 2009, 129(3): 306-311.DOI:10.1016/j.ijfoodmicro.2008.12.015.
[42] ROSS T. Indices for performance evaluation of predictive models in food microbiology[J]. Journal of Applied Bacteriology, 1996, 81(5):501-508. DOI:10.1111/j.1365-2672.1996.tb03539.x.